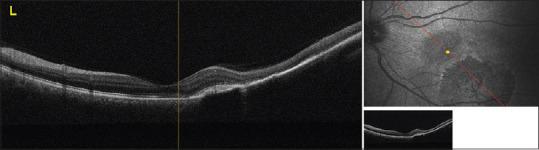
https://cdn.ncbi.nlm.nih.gov/pmc/blobs/8cee/7727947/51824ceb26fe/IJO-68-2288-g005.jpg

从无症状病变到威胁视力的病症:视网膜色素上皮先天性肥大并发脉络膜新生血管膜。
From an asymptomatic lesion to a vision-threatening condition: Congenital hypertrophy of the retinal pigment epithelium complicated by choroidal neovascular membrane.
作者信息
Gun Raziye Donmez, Akcay Güzide, Kanar Hatice Selen, Şimşek Şaban
机构信息
Department of Ophthalmology, Kartal Doctor Lütfi Kırdar Training and Research Hospital, Istanbul, Turkey.
出版信息
Indian J Ophthalmol. 2020 Oct;68(10):2288-2290. doi: 10.4103/ijo.IJO_2185_19.
We reported a case of congenital hypertrophy of the retinal pigment epithelium (CHRPE) complicated by choroidal neovascular membrane (CNVM). A 41-year-old woman presented to our clinic with visual loss in the left eye. She was diagnosed as CHRPE complicated by a CNVM. The patient was treated with 2 consecutive monthly intravitreal aflibercept (IVA) injections. The best-corrected visual acuity (BCVA) improved and stabilized at 6/6. Subretinal fluid depending on CNVM resolved completely. CHRPE complicated by CNVM in the macular area is a rare condition and these cases can be treated with IVA therapy.
我们报告了一例先天性视网膜色素上皮肥大(CHRPE)合并脉络膜新生血管膜(CNVM)的病例。一名41岁女性因左眼视力丧失前来我院就诊。她被诊断为CHRPE合并CNVM。该患者接受了连续两个月每月一次的玻璃体内注射阿柏西普(IVA)治疗。最佳矫正视力(BCVA)提高并稳定在6/6。依赖于CNVM的视网膜下液完全消退。黄斑区CHRPE合并CNVM是一种罕见情况,这些病例可采用IVA疗法治疗。